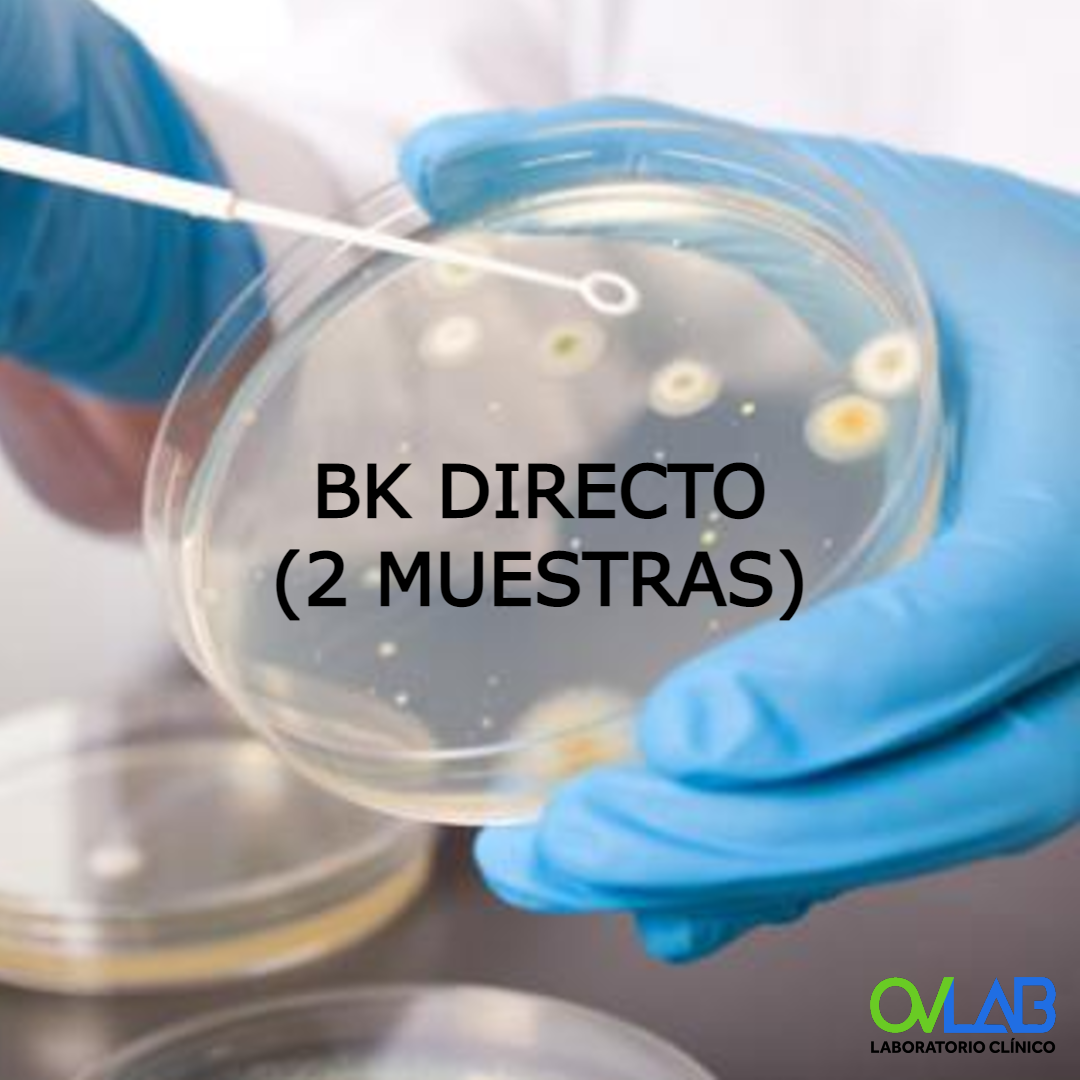

Introducing the bk beauty coupon, your golden ticket to unlocking incredible savings on premium beauty products. Whether you’re a makeup novice or a seasoned pro, these coupons offer you the chance to elevate your beauty game without breaking the bank.
With the latest trends at your fingertips and exclusive discounts in hand, your beauty routine is about to get a fabulous upgrade. Don’t miss out on the opportunity to indulge in high-quality products while enjoying significant savings!
Are you ready to transform your life and elevate your everyday experience? Introducing the revolutionary LifeMaster 360° – the all-in-one solution designed to enhance every aspect of your daily routine, empowering you to live your best life!Imagine waking up each morning with a sense of purpose, equipped with tools that streamline your tasks, inspire your creativity, and boost your well-being.
The LifeMaster 360° isn’t just a product; it’s your personal lifestyle enhancement system that adapts to your unique needs and goals.### What Makes LifeMaster 360° Unique?
1. Smart Integration
The LifeMaster 360° seamlessly syncs with all your devices. Whether it’s your smartphone, tablet, or laptop, stay connected effortlessly and manage your tasks from one central hub. No more juggling multiple apps – we believe in simplicity and efficiency!
2. Personalized Planning
Say goodbye to chaos and hello to organization! With our advanced AI planning assistant, you can create tailored schedules, set reminders, and track your goals with ease. The intuitive interface learns from your habits, suggesting optimizations to help you stay focused and productive.
3. Health and Wellness Monitoring
Your wellness journey starts here! The LifeMaster 360° includes a comprehensive health tracking feature that monitors your physical activity, sleep patterns, and nutritional intake. Get personalized insights and actionable tips to elevate your health and well-being to new heights.
4. Inspirational Content
Need a little motivation? Our curated library is packed with articles, podcasts, and videos from industry leaders and wellness experts. Discover new strategies for personal growth, mindfulness practices, and productivity hacks that inspire you to push past your limits.
5. Community Support
Join a vibrant community of like-minded individuals! Share your achievements, seek advice, and find accountability partners. The LifeMaster 360° fosters a supportive environment where together, we can achieve greatness.### The Benefits of LifeMaster 360°
Enhanced Productivity
With tools designed to eliminate distractions and keep you organized, you’ll find yourself getting more done in less time. Say goodbye to procrastination and hello to efficiency!

Improved Mental Clarity

Gain control over your distractions with focused work sessions. Our techniques are designed to help you achieve flow, allowing your mind to thrive and your creativity to flourish.
Stronger Connections
Cultivate relationships that matter. With the LifeMaster 360°, you can easily maintain connections with friends, family, and colleagues, ensuring you’re never isolated in your pursuits.
Empowered Mindset
Embrace a growth mindset with access to resources that challenge you and empower your journey. The LifeMaster 360° encourages resilience and positivity, making it easier to overcome obstacles.### Frequently Asked Questions#### How does LifeMaster 360° work?The LifeMaster 360° works by integrating various aspects of your life into a singular platform. Using AI technology, it adapts to your preferences and habits, providing you with personalized recommendations and reminders to improve your overall efficiency and well-being.#### Is it easy to use?Absolutely! Our user-friendly interface is designed for everyone, regardless of technical expertise.
You’ll be guided through the setup process, and our support team is always available to help you along the way.#### Can I access the LifeMaster 360° on multiple devices?Yes! The LifeMaster 360° is cloud-based, meaning you can access your personalized dashboard from any device at any time. Stay connected and organized wherever you go!#### What makes LifeMaster 360° different from other productivity tools?LifeMaster 360° goes beyond simple task management.
It combines productivity tools with health monitoring, community engagement, and educational content, making it a holistic solution for your lifestyle.### Join the LifeMaster Revolution Today!Are you ready to take control of your life and begin your journey towards fulfillment and success? Don’t wait any longer! The first 100 customers will receive an exclusive discount and a free one-month membership to our premium content library.Transform your everyday experiences with the LifeMaster 360°.
Embrace the change, harness your potential, and become the best version of yourself. Visit our website now and start your journey towards a well-organized, productive, and fulfilling life. The LifeMaster 360° awaits you!
Expert Answers
How can I use my bk beauty coupon?
You can apply your bk beauty coupon at checkout online or in-store by entering the code provided or showing the coupon to the cashier.
Are there any restrictions on the bk beauty coupon?
Yes, some coupons may have expiration dates and may not be valid on sale items or in conjunction with other promotions.
Where can I find the latest bk beauty coupons?
The latest bk beauty coupons can typically be found on the official website, coupon websites, or through promotional emails.
Can I share my bk beauty coupon with others?
Most coupons are meant for individual use, but check the specific terms and conditions for sharing policies.
Is there a limit to how many bk beauty coupons I can use?
Typically, you can only use one coupon per transaction, but be sure to check the details of each coupon for specific limitations.











